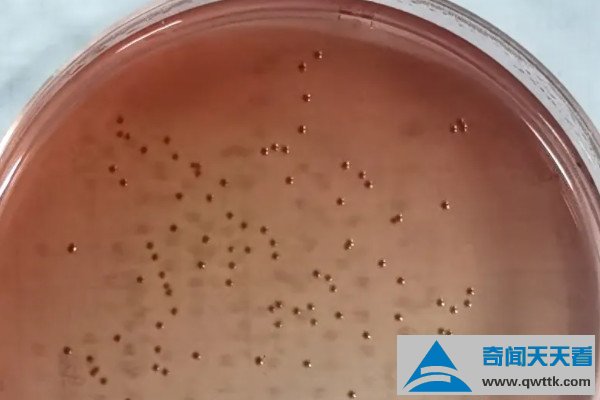

每次情人节、七夕节或者520这种特殊的节日,情侣们都会在各大社交平台秀恩爱,让人直呼神烦,而前不久有一则新词活了,就是“我想让对象买Mac,但他给我买了个Mac”,一下就让人懵了,下面就让小编带着大家去看看mac是什么意思吧。
mac是什么意思
1.苹果电脑

Mac可以代指苹果旗下所有电脑的统称,它的全英文名为“Macintosh”,是苹果公司旗下的一款个人消费型计算机品牌,于1984年正式上线售卖,如今该品牌下的电脑款式有iMac、Macbook、Mac mini等款式,而且每款都是使用macOS系统。
2.彩妆品牌

女性口中的Mac一般是指加拿大的一个彩妆品牌,隶属于雅诗兰黛集团,其全称为M·A·C彩妆,中文名字为魅可,和Mac电脑一样,都是1984年上线售卖的,另外Mac在雅诗兰黛的协助支持下,并以自身的优异性而深受广大女性消费者的喜爱。
3.电脑或设备词汇

当Mac代指电脑词汇时,它可表示手动报警站、消息认证码以及多址接入信道三个内容,其中手动报警站是火灾报警系统中的一个设备类型,其触发条件就是人工手动按下按钮3-5秒中,消息认证码是电脑系统中的保密工具,而多址接入信道是指通信网络的上行链路。
4.专业名词
Mac还可以表示最高容许浓度、最低肺泡有效浓度、平均气动弦、膜攻击复合物、麦康凯琼脂、重大不利变化条款等专业名词,涉及到化学、生物学、经济学、环境学等各科目,其中最低肺泡有效浓度是医学中的专业名词,表示麻醉剂效能的一种定量指标。
5.电视剧人物

MAC也可以表示电视剧《雷欧奥特曼》中宇宙怪物攻击队的英文缩写,因为该小队的英文为Monster Attacking Crew,共有15名正式成员、三个基地以及多项MAC设备,注意MAC队也是奥特曼特摄剧中唯一一个团灭的防卫队。






















